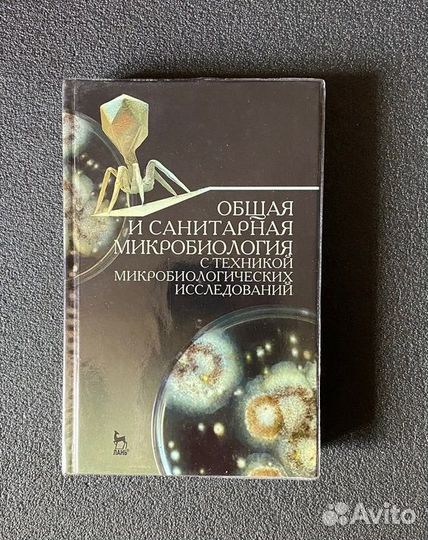
Лабинская Общая и санитарная микробиология

Алгебра, геометрия 7 класс
100 руб.
В нормальном состоянии.
Объвление найдено на сайте avito.ru. Перейдите по ссылке для покупки или просмотра более подробной информации